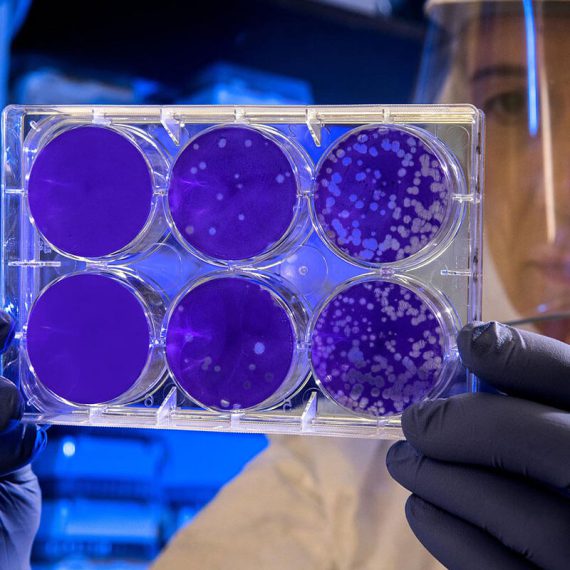

The Issues
One major function of platelets is to contribute to hemostasis: the process of stopping bleeding at the site of interrupted endothelium. They gather at the site and unless the interruption is physically too large, they plug the hole. First, platelets attach to substances outside the interrupted endothelium: adhesion. Second, they change shape, turn on receptors and secrete chemical messengers: activation. Platelets also participate in both innate and adaptive intravascular immune responses.
Thus, platelets transfusions are needed to treat “thrombocytopenia” which is a decrease in platelet concentration that is induced by a large number of diseases, many with a rising incidence due to population
Thus, platelets transfusions are needed to treat “thrombocytopenia” which is a decrease in platelet concentration that is induced by a large number of diseases, many with a rising incidence due to population

The Approach
Today, due to the very low proportion of platelets in the blood and to the complexity of this long and multi steps centrifuge-based manufacturing process, Blood Banks world wide struggle to produce Platelets Concentrates with affordable pricing complying with high level regulatory mandatories. Indeed, Accoustophoresis allows a much softer processing (6 times below shear stress platelets’ activation threshold) than centrifuge methods, and thus to achieve a more efficient sorting and a expected better quality and preservation.
Thus, platelets transfusions are needed to treat “thrombocytopenia” which is a decrease in platelet concentration that is induced by a large number of diseases, many with a rising incidence due to population ageing, such as autoimmune diseases, hematologic malignancies, bone marrow suppression, side effects of heparin based treatment, haemophiliac patients, sickle cell disease, thalassemia, traumas and injuries. In most of countries, over 80% of platelets extraction are proceed by Blood Bank from Whole Blood donations.
Thus, platelets transfusions are needed to treat “thrombocytopenia” which is a decrease in platelet concentration that is induced by a large number of diseases, many with a rising incidence due to population ageing, such as autoimmune diseases, hematologic malignancies, bone marrow suppression, side effects of heparin based treatment, haemophiliac patients, sickle cell disease, thalassemia, traumas and injuries. In most of countries, over 80% of platelets extraction are proceed by Blood Bank from Whole Blood donations.
The Benefits
Pancreas is a key vital organ whose dysfunction, linked to various pathologies, leads to physiological disorders responsible for chronic diseases that severely degrade the quality and life expectancy of patients. Some of these pathologies would require the use of organ transplants. However, since the proportion of rejections from pancreatic transplants is high (more than 45%), the lethal risks of such procedures are too high and organ transplantation is carried out only as a last resort.
Organic acids are metabolic intermediates produced in pathways of central energy production, detoxification, neurotransmitter breakdown, and intestinal microbial activity. Accumulation of specific organic acids in urine often signals a metabolic inhibition or block. This abnormality may be due to a nutrient deficiency.
Organic acids are metabolic intermediates produced in pathways of central energy production, detoxification, neurotransmitter breakdown, and intestinal microbial activity. Accumulation of specific organic acids in urine often signals a metabolic inhibition or block. This abnormality may be due to a nutrient deficiency.
Organic acids are metabolic intermediates produced in pathways of central energy production, detoxification, neurotransmitter breakdown, and intestinal microbial activity. Accumulation of specific organic acids in urine often signals a metabolic inhibition or block. This abnormality may be due to a nutrient deficiency.
To Know more
about our products
Daffodil Pharmachem, Asia’s largest WHO-GMP certified citrate manufacturer, produces over 80 metric tonnes daily, serving trusted global brands across food, pharma, agriculture, and healthcare. Our ingredients quietly enhance products that millions rely on every day—because, for us, chemistry is more than science; it’s our way of Adding Life.
Quick Contact
Daffodil Pharmachem Pvt. Ltd.
A-2304, Privilon, 23rd Floor
B/H Iscon Temple, Ambli-Bopal Road,
S.G. Highway, Ahmedabad-380054
Gujarat, India
©2024 Daffodil pharmachem. All rights reserved